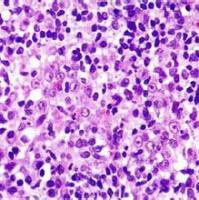
HCE-8962盲肠未分化癌细胞实验

万千商家帮你免费找货
0 人在求购买到急需产品
- 详细信息
- 技术资料
- 提供商:
上海达为科生物科技有限公司
- 服务名称:
软琼脂克隆实验
| 品牌 | 其他品牌 | 产地类别 | 国产 |
|---|---|---|---|
| 应用领域 | 医疗卫生,生物产业,综合 |
软琼脂克隆实验 某些恶性肿瘤细胞,不仅在贴壁状态下能增殖,在悬浮状态下也能增殖,其在软琼脂中形成克隆能力反映其恶性增殖程度,这种方法可用于细胞分化的基础研究和临床肿瘤治疗检验等方面。
软琼脂克隆实验 原理:
细胞接种存活率只表示接种细胞后贴壁的细胞数,但贴壁后的细胞不一定每个都能增殖和形成克隆。而形成克隆的细胞必为贴壁和有增殖活力的细胞。克隆形成率反映细胞群体依赖性和增殖能力两个重要性状。
由于细胞生物学性状不同,细胞克隆形成率差别也很大,一般初代培养细胞克隆形成率弱 ,传代细胞系强;二倍体细胞克隆形成率弱,转化细胞系强;正常细胞克隆形成率弱,肿瘤细胞强。并且克隆形成率与接种密度有一定关系, 做克隆形成率测定时 ,接种细胞定要分散成单细胞暴液,直接接种在碟皿中,持续一周,随时检查,到细胞形成克隆时终止培养。
软琼脂克隆实验 基本步骤:
(1)取对数生长期细胞,用0.25%胰蛋白酶消化并轻轻吹打,使之成为单细胞,作活细胞计数,用含20%胎牛血清的DMEM培养液调整细胞密度至1x106细胞/L。然后根据实验要求作梯度信数稀释。
(2)用蒸馏水分别制备出1.2%和0.7%两个浓度的低溶点琼脂糖液,高压灭菌后,维持在40℃中不会凝固。
(3)按1:1比例使1.2%的琼脂糖和2xDMEM培养基(含有2x抗生素和20%的小牛血清)混合后,取3mL混台液注入直径6cm平皿中(10cm平皿加7-10mL),冷却凝固,可作底层琼脂置CO2温箱中备用。
(4)按1:1比例让0.7%的琼脂糖和2 xDMEM培养基在无菌试管中相混以后,再向管中加入0.2mL的细胞悬液,充分混匀,注入铺有1.2%琼脂糖底层平皿中,逐形成双琼脂层。待上层琼脂凝固后,置入37C 5%CO2温箱中培养10-14天。
(5)把平皿放置在倒置显微镜下,观察细胞克隆数。计算形成率。
软琼脂培养法常用检测肿瘤细胞和转化细胞系。试验中琼脂与细胞相混时,琼脂温度不直超过40°C。接种细胞的密度 每平方厘来不超过35个,一股6cm的平皿接种1000个细胞。正常细胞在悬浮状态下不能增殖,不适用于软琼脂克隆形成试验。
风险提示:丁香通仅作为第三方平台,为商家信息发布提供平台空间。用户咨询产品时请注意保护个人信息及财产安全,合理判断,谨慎选购商品,商家和用户对交易行为负责。对于医疗器械类产品,请先查证核实企业经营资质和医疗器械产品注册证情况。
技术资料暂无技术资料 索取技术资料
上海软琼脂克隆实验
询价